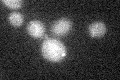
YBR185C
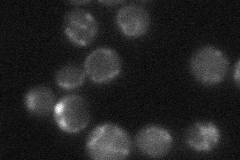
YBR185C

View description
Protein involved in assembly of mitochondrial respiratory complexes; may act as a receptor for proteins destined for export from the mitochondrial matrix to the inner membrane
Localization:
Intensity:
Fold change:
Significance:
-
C’ GFP library in SD
below threshold15.53 -
N' NOP1pr-GFP in SD

mitochondria86.4602 -
N' TEF2pr-mCherry in SD

mitochondria37.4714 -
N' NATIVEpr-GFP in SD
cytosol,mitochondria24.7551 -
N' TEF2pr-VC and Cyto-VN in SD

#N/A0 -
C’ GFP library in SD+DTT

cytosol14.750.94No -
C’ GFP library in SD+H2O2

cytosol16.191.04No -
C’ GFP library in Starvation Media

cytosol17.261.11No -
C’ GFP library on the background of Pup2-DaMP

below threshold -
C’ GFP library on the background of CCT mutant

below threshold15.0490.968617No
